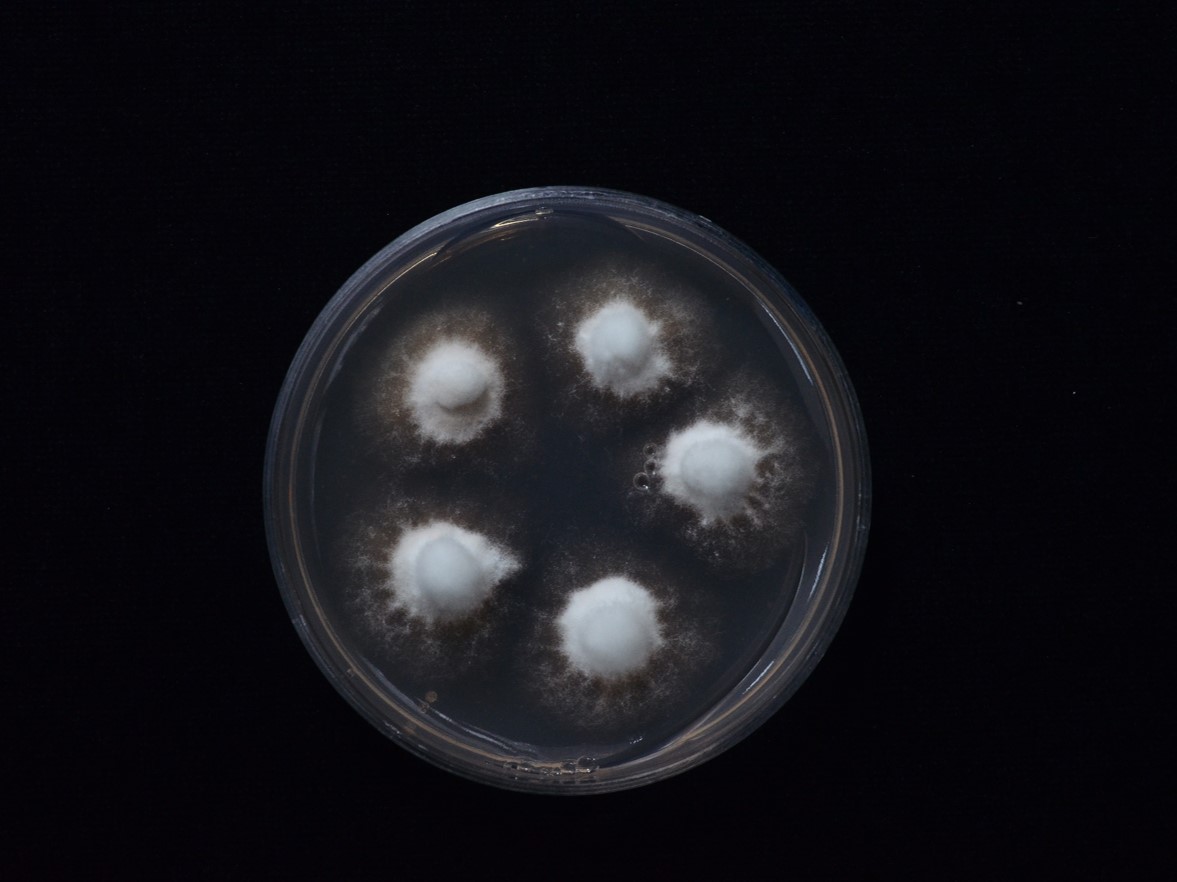

Holotype:
THAILAND, Ranong Province, Khuan Mae Yai Mon Wildlife Sanctuary, 9 Mar. 2011, K. Tasanathai, P. Srikitikulchai, A. Khonsanit, K. Sansatchanon, D. Thanakitpipattana, holotype BBH 29604, ex-type living culture BCC 40861.
Habitat:
Underside of dicotyledonous leaf.
Host:
On Indoxysticus sp. (Thomisidae).
Description:
A long
synnema arising from white mycelial mat covering the host, posterior part of a spider, greyish white, cylindrical, tufted surface, slightly tapering into sterile ovoid tip.
Conidiophores crowded, smooth, enlarging upward into obovoid apices, 10–35 × 3–5 µm, bearing multiple metulae. Metulae broadly obovoid to ellipsoid, 7–10 × 3–4 µm. Phialides borne on metulae, narrowly clavate to cylindrical, thickened at the tip, 7–10 × 2–3 µm. Metulae and phialides together forming wedge-shaped conidial head.
Conidia fusoid or occasionally ovoid with acute ends, 3–6 × 1–2 µm.
Granulomanus synasexual morph observed, occurring on the synnema, arising from the septate hyphae loosely attached to the surface of synnema. Conidiophores distinctly roughened, very short, bearing polyblastic and irregularly shaped phialides with inconspicuous denticles.
Culture characteristics:
Colonies on PDA attaining a diam of 1 cm in 20 d at 25 °C, floccose, white; reverse light brown, darkening with age, starting from the centre.
Reference:
Kuephadungphan W, Petcharad B, Tasanathai K, et al. (2022). Multi-locus phylogeny unmasks hidden species within the specialised spider-parasitic fungus, Gibellula (Hypocreales, Cordycipitaceae) in Thailand. Studies in Mycology101: 245–286.
DOI: https://doi.org/10.3114/sim.2022.101.04.Species |
Strain |
Compound |
Pubchem CID |
Biological activity |
Reference |
|---|
|
Strain |
ITS | LSU | RPB1 | RPB2 | TEF1 |
|---|---|---|---|---|---|
| BCC 40861 | OK040730 | OK040707 | OK040716 | OK040724 | OK040698 |